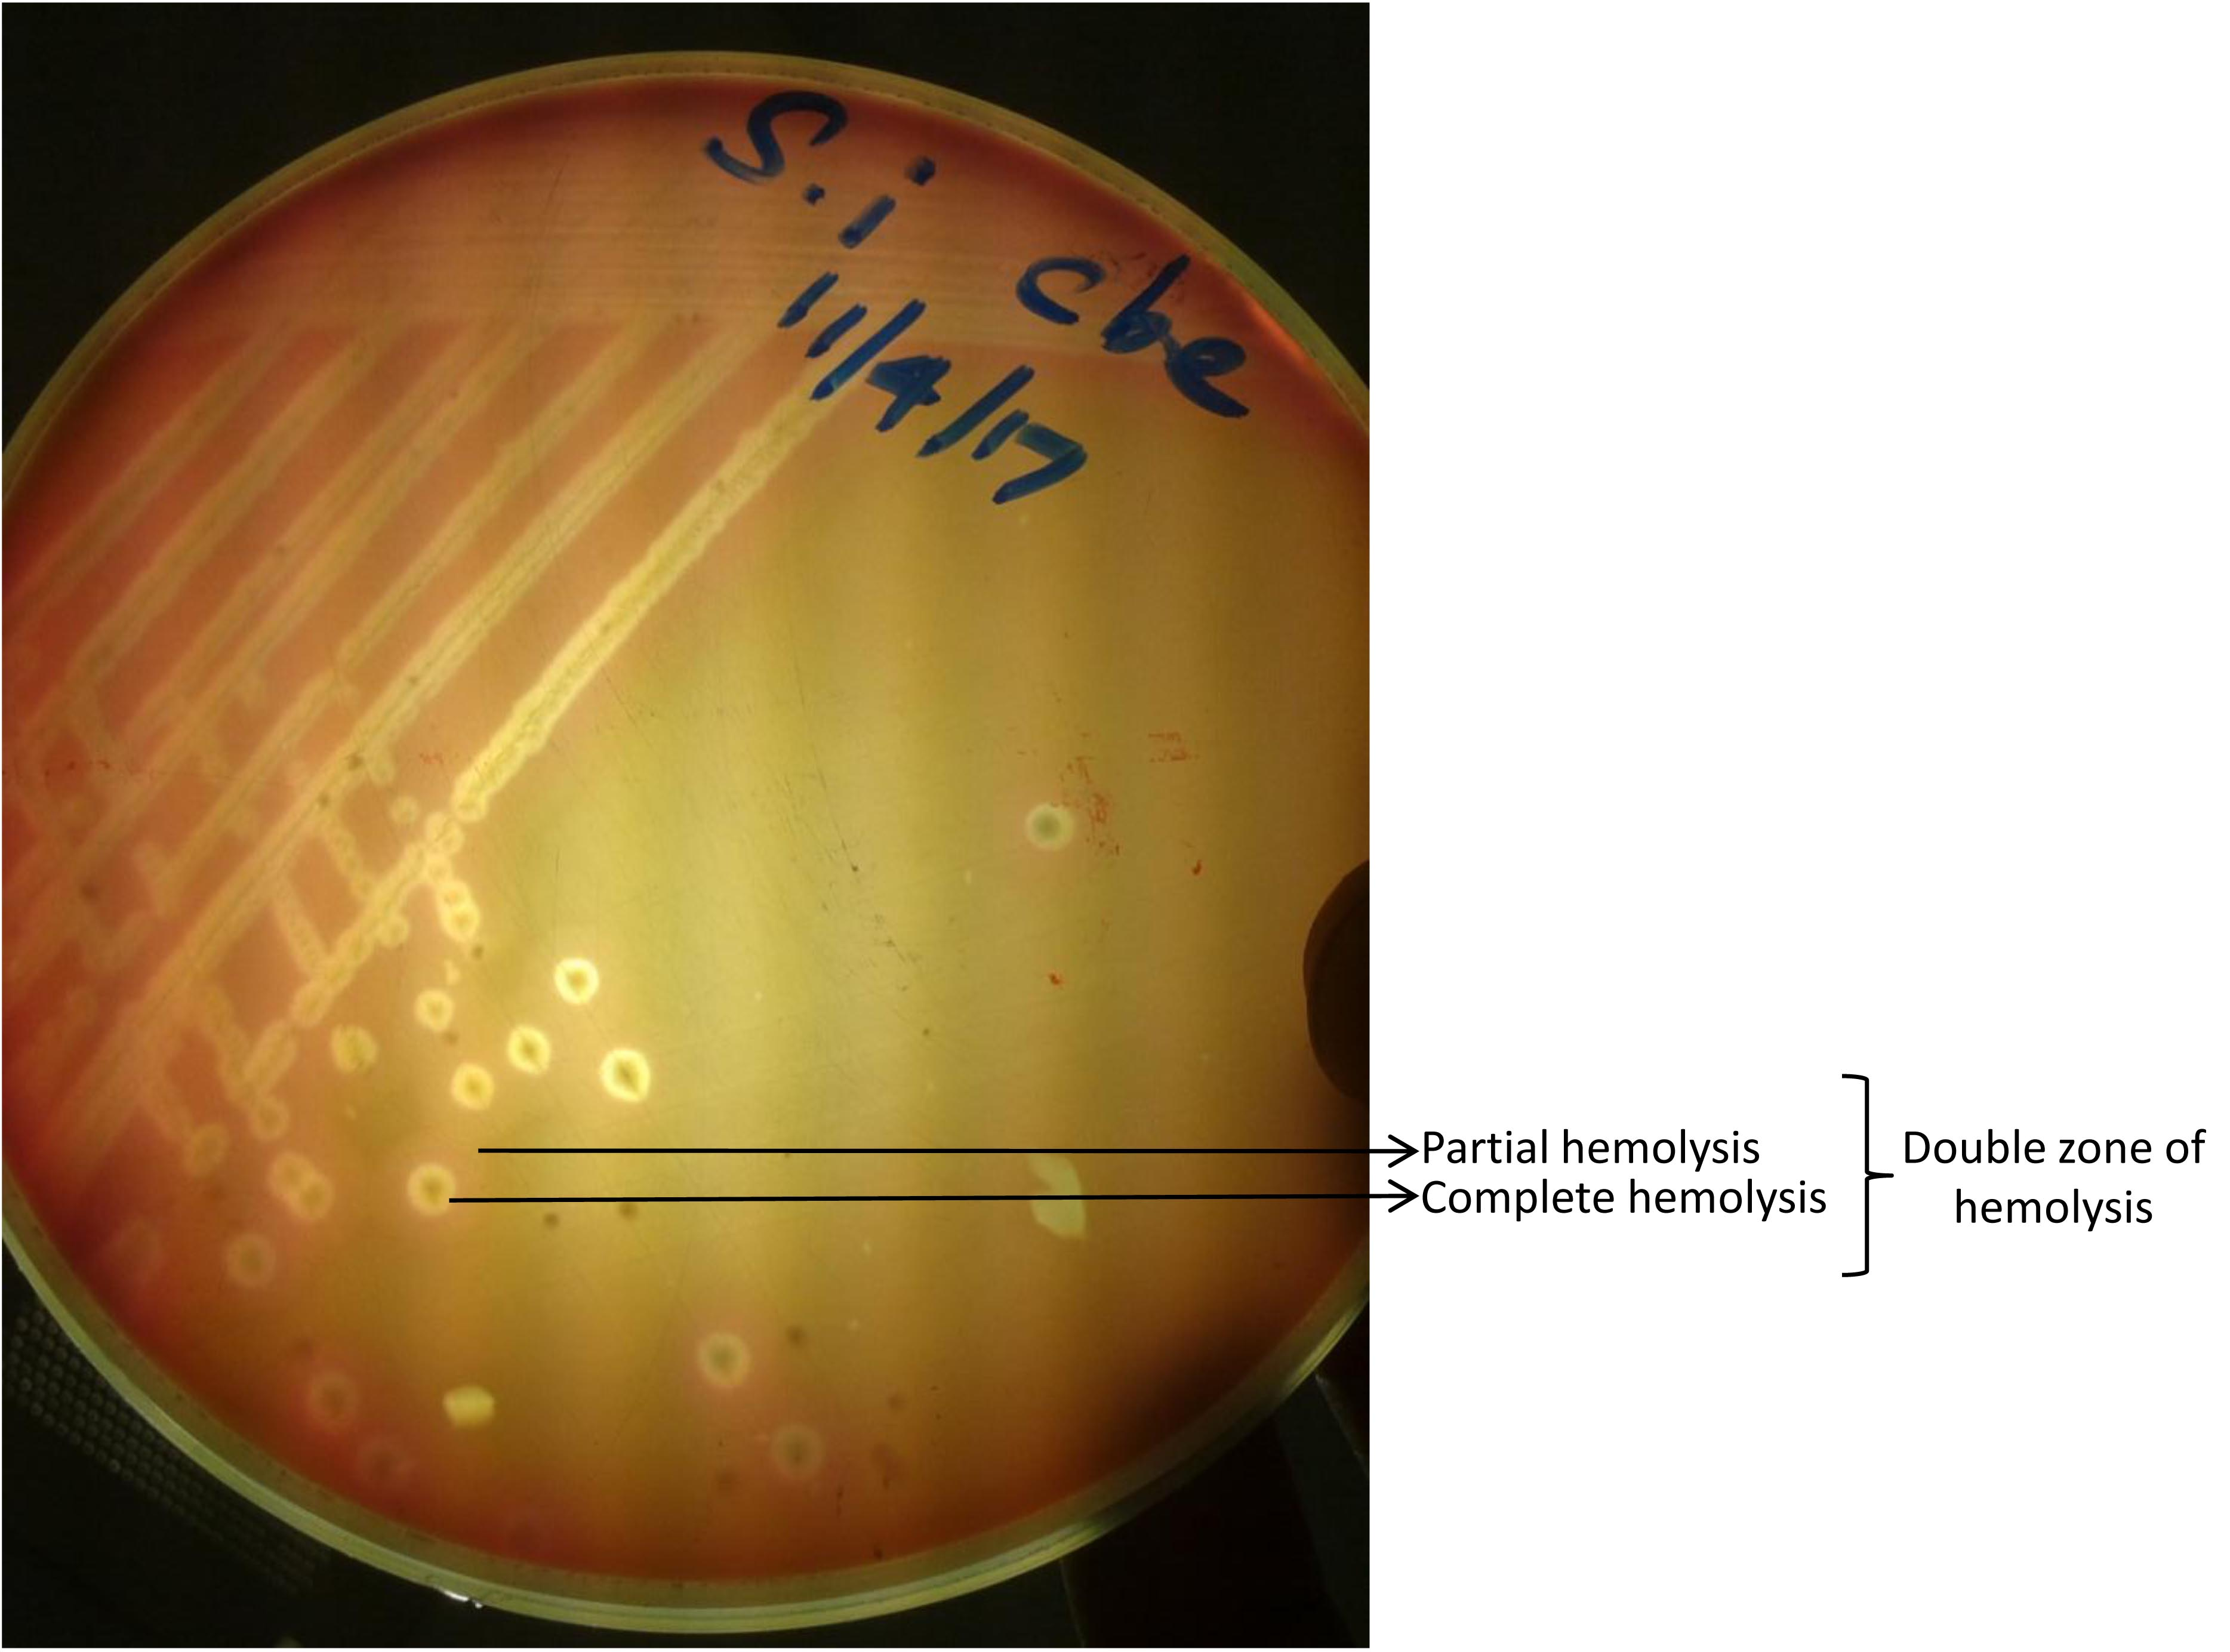

Advances in Animal and Veterinary Sciences
Case Report
Adv. Anim. Vet. Sci. 5(7): 289-292
Figure 1
Double zone hemolytic colonies of C. perfringens on blood agar
Figure 2
Agarose gel electrophoresis image of C. perfringens toxinotyping. M- 100 bp marker, L1- alpha toxin gene PCR product (1167 bp), L2- epsilon toxin gene PCR product (961 bp)